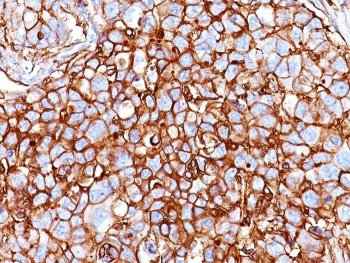
<p><strong data-start="177" data-end="216">CD44 Antibody Breast Carcinoma IHC.</strong> Immunohistochemistry analysis of CD44 / CD44 antigen expression in FFPE human breast carcinoma tissue using <a href="../tds/cd44-antibody-hcam918-v3011">HCAM/918 antibody</a>. Membranous HRP-DAB brown staining is observed in tumor epithelial cells, outlining cell borders and highlighting cell surface localization. The staining pattern demonstrates heterogeneous intensity across the tumor, with subsets of strongly positive cells within the broader population. This distribution supports the use of CD44 as a marker of tumor heterogeneity, cellular organization, and cell surface-associated biology in breast carcinoma tissue.</p>

- Tel: 858.663.9055
 Email: info@nsjbio.com
Email: info@nsjbio.com
- Tel: 858.663.9055
- Email: info@nsjbio.com
CD44 antigen (CD44), also known as homing cell adhesion molecule (HCAM), is a transmembrane glycoprotein that functions as a principal receptor for hyaluronic acid and plays a central role in cell adhesion, migration, and tissue organization. CD44 is localized to the cell membrane where it mediates interactions between cells and the extracellular matrix, supporting tissue architecture and cellular communication. Because of its broad expression across epithelial, lymphoid, and stromal cell types, CD44 antibody reagents are widely used in studies of both normal tissue biology and disease processes.
CD44 is extensively studied in cancer due to its involvement in tumor progression, cell motility, and microenvironmental interactions. Altered CD44 expression is associated with epithelial plasticity, invasion, and tumor heterogeneity, making CD44 antibody tools valuable for evaluating carcinoma structure and disease-related changes. Variant-specific tools such as CD44v6 antibody and CD44v9 antibody further enable targeted investigation of tumor invasion and cancer stem-like cell populations, supporting more precise analysis of CD44-associated biology.
In addition to variant-specific applications, CD44 antibodies are widely used to study functional roles including epithelial cell adhesion, receptor-mediated signaling, and cellular heterogeneity. These capabilities make CD44 a versatile marker for examining tissue organization, tumor biology, and cell surface interactions across a range of research applications.
CD44 functions across multiple biological contexts, acting as both a structural adhesion molecule and a cell surface receptor involved in signaling. CD44 antibody reagents are therefore used to investigate several key functional roles depending on experimental focus.
In epithelial tissues, CD44 supports cell-cell adhesion and maintenance of tissue architecture. Membrane-associated staining highlights cell borders and layered organization, making CD44 antibodies valuable for evaluating epithelial integrity and structural continuity. In tumor biology, CD44 is widely used as a marker of cellular heterogeneity, with differential expression patterns revealing distinct tumor subpopulations and regions of active growth.
CD44 is also strongly associated with cancer stem-like cell populations. Subsets of CD44-positive cells have been linked to enhanced self-renewal capacity and resistance-associated phenotypes, making CD44 a commonly used marker in cancer stem cell research. Tools such as CD44v9 antibody are frequently applied in these studies to identify stress-adapted or stem-like populations within tumors.
In addition to its role in adhesion and cellular identity, CD44 participates in receptor-mediated signaling through interactions with extracellular matrix components and co-receptors at the cell surface. Detection using CD44 antibody reagents allows investigation of membrane-associated signaling interfaces and cell-environment interactions. Together, these roles make CD44 a versatile marker for studying adhesion, signaling, and cellular diversity across biological systems.
CD44 antibody for IHC is one of the most widely used approaches for assessing tissue distribution and cellular localization in formalin-fixed, paraffin-embedded samples. Immunohistochemical staining typically shows strong membranous localization in epithelial cells, outlining cell borders and preserving structural organization within tissues.
In normal tissues, CD44 antibody highlights organized epithelial layers and immune cell populations, reflecting its role in adhesion and leukocyte interaction. In tumor tissues, CD44 staining can identify malignant epithelial cells and reveal variation in expression across tumor regions. This heterogeneous staining pattern supports detailed evaluation of tumor architecture, epithelial differentiation, and spatial organization of cellular subpopulations.
Membrane-dominant staining also reflects the role of CD44 as a cell surface receptor, positioned at the interface between cells and the surrounding microenvironment. This makes CD44 IHC antibody particularly useful for studies of tissue organization, tumor morphology, and cell surface marker distribution.
CD44 antibody for western blot is used to detect protein expression levels and to study variation in CD44 isoforms across different cell types and experimental conditions. Western blot analysis often reveals multiple bands corresponding to alternatively spliced isoforms or post-translationally modified forms of CD44.
As a glycosylated transmembrane protein, CD44 frequently exhibits variation in apparent molecular weight, with bands appearing across a range rather than as a single discrete signal. This reflects differences in glycosylation state and protein processing across tissues and cell lines. CD44 western blot antibody therefore enables analysis of protein expression, modification, and stability under different biological conditions.
This application is particularly useful for investigating regulation of CD44 in cancer biology, immune signaling, and cellular stress responses, allowing comparison of expression across tissues and experimental systems.
CD44 antibody for IF enables visualization of protein localization at the cellular and subcellular level. Immunofluorescence staining typically shows membrane-associated signal outlining cell-cell contacts, consistent with CD44 localization at the plasma membrane and its role in adhesion and extracellular matrix interaction.
This approach is valuable for studying spatial organization, cell morphology, and dynamic changes in protein distribution. CD44 IF antibody is often used in co-localization studies to examine interactions with cytoskeletal or junctional proteins, providing insight into structural organization and membrane-associated processes.
Heterogeneous signal intensity across cell populations can also reflect variation in CD44 expression levels, supporting analysis of cellular diversity and subpopulation structure in cultured cells and tissue-derived samples.
Alternative splicing of the CD44 gene produces multiple variant isoforms, commonly referred to as CD44v proteins, which exhibit distinct functional properties. Among these, variants such as CD44v3, CD44v4, as well as clinically relevant forms like CD44v6 antibody and CD44v9 antibody, are associated with different aspects of cell signaling, adhesion, and tumor biology.
These variant isoforms contribute to diverse biological functions depending on tissue context and cellular state. Some are linked to epithelial differentiation and microenvironmental interaction, while others are associated with tumor invasion, progression, and cellular adaptation to stress. For example, CD44v6 antibody is commonly used in studies of tumor invasion and metastatic behavior, whereas CD44v9 antibody is frequently applied in research focused on cancer stem-like cell populations and resistance-associated phenotypes.
Variant-specific CD44 antibody products enable targeted investigation of these distinct biological roles, supporting more precise analysis of CD44-mediated signaling, cell adhesion, and tissue organization across different experimental systems and disease models.
CD44 antibody products support a wide range of experimental approaches focused on cell adhesion, tumor biology, and immune function. Because CD44 is involved in multiple biological processes, its detection provides insight into both normal physiology and disease-related changes.
Researchers use CD44 antibody reagents to:
- Assess tissue architecture and epithelial organization
- Evaluate tumor structure and cellular heterogeneity
- Study cell adhesion and extracellular matrix interactions
- Examine immune cell distribution and localization
- Analyze changes associated with tumor progression and cellular plasticity
These applications make CD44 a valuable marker for studying complex biological systems across multiple research fields.
CD44 functions within a broader network of adhesion and signaling molecules. Related targets often studied alongside CD44 antibody include:
- Beta-catenin (CTNNB1) - links adhesion complexes to the actin cytoskeleton
- Alpha-catenin (CTNNA1) - stabilizes adherens junctions
- N-cadherin (CDH2) - associated with mesenchymal transition
- Vimentin (VIM) - marker of cytoskeletal remodeling and cellular plasticity
These markers are frequently used together to study epithelial organization, cellular transitions, and changes in cell state.
CD44 antibody is a versatile tool for studying cell adhesion, tissue organization, and disease-related changes across multiple biological systems. Whether used for immunohistochemistry, western blot, or immunofluorescence, CD44 detection provides valuable insight into epithelial structure, immune function, and tumor biology. The availability of variant-specific reagents, including CD44v6 and CD44v9 antibodies, further enhances the ability to investigate tumor progression and cellular heterogeneity.
A selection of CD44 antibody products, including antibodies optimized for IHC, western blot, and immunofluorescence applications, is shown below to support a wide range of research needs.
For a broader selection of related markers, explore our CD Antibodies page covering cluster of differentiation proteins used in immune profiling and cancer research.
Researchers investigating immune cell trafficking, inflammatory signaling networks, and extracellular matrix interactions may also be interested in our Immunology Antibodies landing page featuring cytokines, adhesion molecules, and host defense related proteins.
Browse the complete collection of research antibodies on our Antibodies landing page.
CD44 Antibody Breast Carcinoma IHC. Immunohistochemistry analysis of CD44 / CD44 antigen expression in FFPE human breast carcinoma tissue using HCAM/918 antibody. Membranous HRP-DAB brown staining is observed in tumor epithelial cells, outlining cell borders and highlighting cell surface localization. The staining pattern demonstrates heterogeneous intensity across the tumor, with subsets of strongly positive cells within the broader population. This distribution supports the use of CD44 as a marker of tumor heterogeneity, cellular organization, and cell surface-associated biology in breast carcinoma tissue.